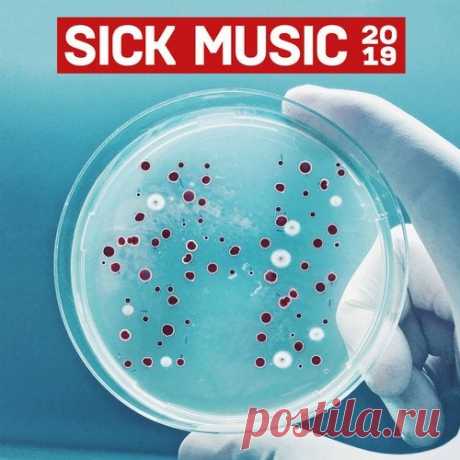

The police
audioclub.store

Loopmasters Dub and Reggae Sirens MULTiFORMAT-AUDIOSTRiKE | 351 MB
Whoop Whoop it’s the sound of the police as turn on the blues and twos for an alarming collection of Dub & Reggae Sirens soaked in feedback delays and space reverbs ready to drop straight into your Dub inspired productions and sets.
pop-mp3.ru

01. Burn the House Down 02. Cinderella 03. Broken Dreams 04. Chain Gang 05. Watching Life's Wheels 06. Yippee Ki Yay 07. A Poor Boy 08. Thought Police 09. Everybody's Somebody Tonight 10. Bold 'N' Easy 11. Hold Back the Night 12. Freelance Fiend 13. High Danger Leaf Hound 00:56:20 2025 13 MP3 409
skachat-igru-torrent.ru

Autobahn Police Simulator 2 cкачать торрент Симуляторы бесплатно | Лучшие игры 2024
lenta.ru

Полицейские нашли в болоте останки подростка возрастом более двух тысяч лет. В Ирландии полицейские нашли в болоте останки подростка, пролежавшие там более двух тысяч лет. Об этом сообщили на сайте правоохранительных органов The Police Service of Northern Ireland (PSNI). Археологи-криминалисты обнаружили, что возраст мужчины был от 13 до 17 лет. Он жил в железном веке около 500 года до н.э.
gazeta.ru

Сотрудники аэропорта пытались провезти в багажном отделении самолета 100 кг кокаина. Сотрудники сиднейского аэропорта пытались ввезти в Австралию крупную партию кокаина на сумму 40 миллионов долларов. Об этом сообщает австралийская федеральная полиция (Australian Federal Police, AFP). В Сиднее задержали пятерых участников ...
lenta.ru

Около «Аллеи славы» в Голливуде вспыхнул пожар. В Лос-Анджелесе недалеко от Голливудского бульвара («Аллеи славы») вспыхнул пожал. Кадры опубликовало Police Frequency в Telegram-канале. По информации издания, возгорание началось в лагере на Эль-Сентро перед зданием LA Fitness. На кадрах видно, как район возгорания заполонил дым. Данных о пострадавших не поступало.
bastyon.com

Bastyon: First Fully Decentralized Social Network on Blockchain A Revolutionary anti-censorship decentralized publishing and social platform. Based on the blockchain technology, it runs on a set of computers around the world, not controlled by any single entity. Self-policed by users with good reputation where nobody records your keystrokes, viewing habits or searches.
lenta.ru

Нидерландские F-35 прибыли в Польшу для патрулирования неба. Вице-премьер, министр национальной обороны Польши Мариуш Блащак рассказал, что истребители F-35 прибыли в Польшу из Нидерландов, чтобы принять участие в миссии усиленного воздушного патрулирования НАТО. «Они будут поддерживать Войско Польское в защите неба в рамках миссии НАТО Enhanced Air Policing», — подчеркнул он.
freednb.com

BEATSME - BeatsMe LP 2019 • BeatsMe — Anti matter 3:31• BeatsMe — Bounce 43 4:11• BeatsMe — FUCK THE POLICE 4:50• BeatsMe — Not Again (Bounce) 4:19• BeatsMe — Not Alone 3:56• BeatsMe — Right Now 3:34• BeatsMe — Stay Here 4:03onlineTurbo | Nitro"herunterladen" Style BreaksReleased 30/09/2019Quality MP3/320kbpsLabel
bastyon.com

Bastyon: First Fully Decentralized Social Network on Blockchain A Revolutionary anti-censorship decentralized publishing and social platform. Based on the blockchain technology, it runs on a set of computers around the world, not controlled by any single entity. Self-policed by users with good reputation where nobody records your keystrokes, viewing habits or searches.
bastyon.com

Bastyon: First Fully Decentralized Social Network on Blockchain A Revolutionary anti-censorship decentralized publishing and social platform. Based on the blockchain technology, it runs on a set of computers around the world, not controlled by any single entity. Self-policed by users with good reputation where nobody records your keystrokes, viewing habits or searches.
bastyon.com

Bastyon: First Fully Decentralized Social Network on Blockchain A Revolutionary anti-censorship decentralized publishing and social platform. Based on the blockchain technology, it runs on a set of computers around the world, not controlled by any single entity. Self-policed by users with good reputation where nobody records your keystrokes, viewing habits or searches.
freednb.com

DJ Profit - Bassland Show DFM (19.08.20 - 28.10.2020) 11 ЭФИРОВ ТреклистыBassland Show @ DFM (02.09.2020) — Special guest Distant Future aka Paperclip aka Konstructor1. Bad company — Digital Nation2. Ulterior motive — Tape Pack3. Concord Dawn — Don’t Tell Me4. Dj Limited — Bad Tune5. Aphrodite — Style From Dark Side6. John Holt — Police in Helicopter (Benny L
Подгруженный файл

https://www.foxnews.com/politics/paul-pelosi-allegedly-slurred-speech-drug-system-handed-police-privilege-card-dui-bust
Paul Pelosi, the multimillionaire husband of House Speaker Nancy Pelosi, allegedly had a drug in his system, addressed officers with slurred speech, and tried to hand them a police courtesy card during his May arrest on DUI charges, according to court documents.
freednb.com

VA - SICK MUSIC 2019 (LP) 2019 1. Fred V – Burning Me (03:23) 2. Degs – Poveglia (feat. De:Tune) Whiney Remix (04:08) 3. London Elektricity – Funkopolis (05:20) 4. S.P.Y – Dusty Fingers (feat. Diane Charlemagne) Metrik Remix (04:35) 5. John Holt – Police in Helicopter (Benny L Remix) (04:26) 6. Inja & Whiney – Be My Cure
creativemarket.com
Cartoon Raccoon Cop. T-Shirt, PNG, SVG.
An illustration of a brave police raccoon, with handcuffs on his belt and a pistol in his hood. Unique design, Childish illustration. Use the product to print on clothing, accessories, holiday decorations, labels and stickers, nursery decorations, invitation cards, scrapbooking, diaries and more.
-------------------------------------------
EPS_10, SVG, JPG, PNG file transparent with a resolution of 300 dpi, 15000 X 15000.